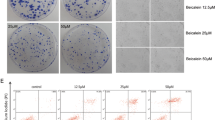

Abstract
The major reason responsible for the poor prognosis of osteosarcoma is the malignant proliferation of osteosarcoma cells. The activated Wnt/β-catenin signaling induces c-MYC gene transcription and results in osteocytes’ carcinomatous change, which contributes to osteosarcoma development, so c-MYC gene is one of the therapeutic targets. The role of multiple botanical extracts in the expression of β-catenin’s target gene c-MYC in osteosarcoma MG-63 cells was tested by cellomics high content screening. Baicalein was identified as the most effective one which can inhibit the proliferation and promote the apoptosis of MG-63 cells in a dose-dependent manner by cell counting kit-8 test and fluorescence-activated cell sorting, respectively. This process was associated with the decreased levels of β-catenin and its target gene c-MYC, identified by q-PCR and Western blotting, respectively. When MG-63 cells were treated with both baicalein and JNK inhibitor SP600125, the apoptosis and expression of c-MYC were not significantly decreased. After the construct pcDNA3.1-BANCR (BRAF-regulated lncRNA 1) was transfected into MG-63 cells, RT-PCR, Western blotting and CCK-8 assay showed that BANCR was positively correlated with baicalein. These results indicated that baicalein inhibited osteosarcoma cell proliferation and promoted apoptosis by targeting c-MYC gene through Wnt signaling, in which JNK and BANCR were also involved as well as β-catenin, suggesting a new potential mechanism for us to better understand the inhibiting effect of baicalein on osteosarcoma.
Similar content being viewed by others
Avoid common mistakes on your manuscript.
Introduction
Osteosarcoma (OS) is an aggressive malignant neoplasm arising from primitive transformed cells of mesenchymal origin that exhibit osteoblastic differentiation and produce malignant osteoid [1]. An unknown etiology, high genetic instability of OS cells, a wide histological heterogeneity, lack of biomarkers, high local aggressiveness, and a rapid metastasizing potential create pivotal questions to be answered [2]. OS progresses through a series of genetic and epigenetic aberrations that cause dysregulation of key cell signaling pathways involved in growth, malignant behavior and therapy-resistance [3]. Most importantly, that responsible for the poor prognosis of osteosarcoma disease is the malignant proliferation of OS cells [4].
Wnts are a family of 19 secreted glycoproteins that have crucial roles in the regulation of diverse processes, including cell proliferation, survival, migration and polarity, specification of cell fate, and self-renewal in stem cells [5]. Ever since its initial discovery, Wnt signaling has had a strong association with cancer [6]. The canonical Wnt pathway (or Wnt/β-catenin pathway) is the Wnt pathway that causes an accumulation of β-catenin in the cytoplasm and its eventual translocation into the nucleus to act as a transcriptional coactivator of transcription factors. Without Wnt signaling, the β-catenin would not accumulate in the cytoplasm since a destruction complex would normally degrade it [7]. The c-MYC protooncogene, a target gene of Wnt/β-catenin signaling pathway, regulates expression of numerous other genes that control key cellular functions, including cell growth and cell cycle progression [8]. Deregulated c-MYC expression resulting from various types of genetic alterations leads to constitutive c-MYC activation in a variety of cancers and promotes oncogenesis.
Multiple strategies for targeting Wnt signaling-ranging from small molecules to blocking antibodies and peptide agonists and antagonists—are now in development, thus paving the way for initial clinical trials using Wnt modulators in cancer patients. Baicalein is a bioactive compound that can be obtained from several species of the genus Magnolia (such as officinalis, obovata, and grandiflora) of Magnoliaceae family [9], which has been shown to exhibit pleiotropic anticancer effects in many cancer types. It was observed that treatment of non-small cell lung cancer (NSCLC) cells with baicalein degraded cytosolic β-catenin, reduced nuclear accumulation of β-catenin and down-regulated matrix metalloproteinase (MMP)-2 and MMP-9, which are the down-stream targets of β-catenin and play a crucial role in cancer cell metastasis [10]. Baicalein inhibits non-small cell lung cancer cells migration by targeting PGE2-mediated activation of Wnt/β-catenin signaling [10].
Considering the aforementioned important roles of Wnt signal pathway, β-catenin and its target gene c-MYC, we hypothesized that baicalein could inhibit osteosarcoma cells proliferation and promote apoptosis by targeting c-MYC gene via Wnt signaling. In this study, we evaluated the role of different botanical extracts on the expression of c-MYC, and further explored whether baicalein exerts its effect through inhibiting Wnt signaling pathway. Besides, the role of a lncRNA BANCR that is possibly involved in this pathway was also clarified.
Materials and methods
Reagents and antibodies
Purified baicalein, Aesculin, Boswellia extract, 37 saponins, Astragaloside, Ginsenosides, Nuciferine, Rutin, Glycyrrhizinate, Kudzu flavonoids, Lycopene, Dandelion flavonoids, Gypenosides, Salicin, and EOB were purchased from Quality Phytochemicals, LLC (Edison, NJ, USA). The antibodies specific for β-catenin (#9562), c-MYC (#9402), GSK-3β (#9315L), CK1 (#2655), APC (#2504), DKK1 (#4687S), and GAPDH (#2118) were purchased from Cell Signaling Technology (Beverly, MA, USA) (serial number: 9562, 9402 and 2118, respectively). JNK inhibitor SP600125 was from Selleck (Houston, TX, USA). Monoclonal anti-GSK-3β, anti-CK1 and anti-catenin antibodies were from BD Transduction Labs (San Diego, CA, USA). Monoclonal anti-Axin, anti-APC, anti-JNK, anti-p-JNK (Thr183/Tyr185), and anti-GAPDH antibodies were from Cell Signaling Technology (Beverly, MA, USA). Anti-c-MYC monoclonal antibody was from Santa Cruz Biotechnology (Santa Cruz, CA, USA). PI/Annexin V antibody kit (C1062) for fluorescence-activated cell sorting (FACS) was from Beyotime Biotech Company (Shanghai, China).
Immunofluorescence
All the botanical extracts were, respectively, dissolved in DMSO to a final concentration of 40 μg/ml. MG-63 cells and osteoblast SV-HFO [Osteosarcoma cell lines, obtained from the American Type Culture Collection (Manassas, VA, USA)] were cultured in RPMI-1640 medium supplemented with 10 % fetal bovine serum (FBS, Invitrogen, CA, USA), 1 % glutamine (Invitrogen), 1 % penicillin–streptomycin (Invitrogen) at 37 °C in 5 % CO2, using 384-well plates (4000 cells/well) for 24 h. After these botanical extract solutions were, respectively, added into the medium, the cultivation continued for another 24 h. Following the various treatments, the adherent cultured cells were washed twice with phosphate buffered saline (PBS) and fixed in a paraformaldehyde solution (4 % in PBS, pH 7.4) for 30 min at 4 °C. The fixed cultures were then washed twice with PBS, treated with permeabilization solution (0.1 % Triton X-100 in 0.1 % sodium citrate) on ice for 2 min, and incubated in blocking buffer (3 % bull serum albumin (BSA) in Tris-buffered saline tween (TBST) for 1 h. The cells were then incubated with the indicated antibody in TBST containing 3 % BSA overnight at 4 °C. After incubation, the cells were washed and incubated with the indicated fluorescence-labeled secondary antibodies in the dark at 37 °C for 1 h. After washing, the cells were observed under a fluorescence microscope. Confocal images were captured under a Leica, TCS SP5 confocal microscope (Leica Microsystems, Mannheim, Germany).
Cell viability assay
Cell counting kit-8 (CCK-8, Dojindo, Japan) proliferation assays were used to evaluate the inhibiting effects of baicalein on MG-63 cells. A total of 4000 MG-63 cells were plated into each well of a 384-well plate and cultured for 24 h. After this the culture medium was removed, different concentrations of baicalein media were added, and the MG-63 cells were cultured for 1, 2, or 3 days. Subsequently, 10 µl of CCK-8 solution was added to each well and incubated for 3 h, and a microplate reader was used to detect the absorbance at 450 nm.
Cell apoptosis assay
Cell apoptosis was measured using an Annexin V/fluorescein isothiocyanate (FITC) apoptosis detection kit (Beyotime). The MG-63 cells were harvested after indicated treatments with trypsin (0.25 %), and a single cell suspension was prepared. Cells were then washed with PBS and pelleted by centrifugation at 1000 rpm for 5 min. The cells were resuspended in binding buffer (10 mmol/l HEPES/NaOH, pH 7.4, 140 mmol/l NaCl, 5 mmol/l CaCl2) and the cell density was adjusted to 5 × 105 cells/ml. A 95-µl aliquot of the cell suspension was added to 5 µl Annexin V-FITC, and then cells were incubated for 10 min at room temperature in the dark. To obtain a final concentration of 1 µg/ml, the suspension was then washed with PBS and resuspended in 190 µl binding buffer before adding 10 µl propidium iodide (PI). The samples were examined by flow cytometry (BD FACS Vantage; BD Sciences, San Jose, CA, USA) with a 488 nm excitation source. The test wavelength was 515 nm for FITC and 560 nm for PI. The results were analyzed using cell quest software (BD Sciences) to determine the rate of apoptosis in the lower right quadrant.
Western blotting
To investigate the expression changes of the apoptosis-related protein in MG-63 cells exposed to baicalein, MG-63 cells were exposed to different concentration of baicalein with or without SP600125 (50 μmol/l) for 24 h at 37 °C. Then cells were harvested, washed twice with ice-cold PBS and lysed using cell lysis buffer (Beyotime). The lysates were harvested and centrifuged at 12,000 rpm at 4 °C for 5 min. Protein concentrations of cell lysates were measured using the BCA protein assay kit (Beyotime).
Total protein samples (20 μg) were loaded onto a 12 % of SDS-polyacrylamide gel for electrophoresis, and then transferred onto PVDF membranes (Millipore, Billerica, USA) at 0.8 mA/cm2 for 2 h. Membranes were blocked with blocking solution (1 % BSA in PBS plus 0.05 % Tween-20) at room temperature for 2 h. After incubation overnight at 4 °C with primary antibodies at a 1:1000 dilution in blocking solution (Beyotime), membranes were incubated for 1 h at room temperature with alkaline phosphatase peroxidase-conjugated secondary antibodies. Detection was performed by the BCIP/NBT Alkaline Phosphates Color Development Kit (Beyotime) according to the manufacturer’s instructions. Bands were recorded by a digital camera (Canon, EOS350D, Tokyo, Japan).
Quantitative RT-PCR
Osteosarcoma cell lines were used to isolate total RNA using RNeasy kit according to the manufacturer’s protocol (Qiagen, Valencia, CA, USA). Total mRNA was extracted from cells using the Trizol Reagent (Invitrogen, Cat. 15596-026) and protocol provided by the manufacturer. Briefly, first-strand cDNA was reverse-transcribed from 1 μg total RNA using the Super-Script First-Strand cDNA System (Invitrogen), and was amplified by Platinum SYBR Green qPCR SuperMix-UDG (Invitrogen). A master mix was prepared for each PCR reaction, which included Platinum SYBR Green qPCR SuperMix-UDG, forward primer, reverse primer, and 10 ng of template cDNA. PCR conditions were 5 min at 95 °C, followed by 40 cycles of 95 °C for 30 s, 55 °C for 30 s, and 72 °C for 30 s.
The forward and reverse primer sequences were as follows:
-
β-catenin 5′-TTCGCACAGTTCTACGTGCT-3′ (sense), 5′-GGTGTGCACGAACAAGCAAT-3′ (antisense);
-
c-MYC 5′-CCCTCCACTCGGAAGGACTA-3′ (sense), 5′-GCTGGTGCATTTTCGGTTGT-3′ (antisense);
-
GADPH 5′-AATGGGCAGCCGTTAGGAAA-3′ (sense), 5′-GCGCCCAATACGACCAAATC-3′ (antisense);
-
BANCR [11], 5′-ACAGGACTCCATGGCAAACG-3′ (sense), 5′-ATGAAGAAAGCCTGGTGCAGT-3′ (antisense).
Plasmid construction and cell transfection
A long non-coding RNA named BANCR was introduced into pcDNA3.1 vector (Invitrogen). BANCR was ectopically expressed after pcDNA3.1-BANCR transfection using Lipofectamine 2000 (Invitrogen). An empty pCDNA3.1 vector was used as a control. The expression levels of BANCR were measured by quantitative RT-PCR. Plasmid vectors for transfection, including pcDNA3.1-BANCR and pcDNA3.1, were extracted with a Midiprep kit (Qiagen) and transfected into MG-63 cells. According to the manufacturer’s instructions, fusion and transfection of MG-63 cells were performed using Lipofectamine 2000 (Invitrogen) during the cultivation in six-well plates. After transfection for 48 h, cells were collected for cell viability assay, and lysed for quantitative PCR or Western blot analysis.
Statistical analysis
For cell apoptosis and viability assays, the data were compared among groups separately through one-way analysis of variance (ANOVA) using GraphPad Prism version 4.00 for Windows software (GraphPad Software, San Diego, California. www.graphpad.com.). A two-tailed p value of less than 0.05 was considered statistically significant.
Results
The inhibiting effect of various botanical extracts on the c-MYC expression in MG-63 cells
Firstly, we tested the role of various botanical extracts on the expression of the β-catenin target gene c-MYC using cellomics high content screening. As shown in Fig. 1, the osteosarcoma MG-63 cells treated with baicalein for 24 h in Boyden chamber and resulted in a greater inhibition of c-MYC expression compared with other botanical extract. Other botanical extracts seemed cannot inhibit the expression of the c-MYC gene, although a little bit decreased expression of c-MYC in 37 saponins-treated MG-63 cells was observed. The results suggested that baicalein was the most effective botanical extract which can inhibit c-MYC expression.
Baicalein induced the degradation of β-catenin
C-MYC is one of the target genes of β-catenin, down-regulated c-MYC indicated that β-catenin protein is likely to be degraded by baicalein. In order to confirm this conjecture, we detected the expression of GSK-3β, CK1, APC, and Axin by Western blotting that contributed to the process of degradation of β-catenin. As shown in Fig. 2a, upregulated expressions of the 4 proteins were seen after treatment with baicalein. Furthermore, with the increase of drug concentration, the protein expression also increased gradually. These results suggested that baicalein can inhibit the expression of c-MYC by promoting the degradation of β-catenin.
a Expression analysis of GSK-3β, CK1, APC, and Axin by Western blotting in MG-63 cells treated with or without baicalein. b The effect of various concentrations of baicalein on the proliferation of osteosarcoma MG-63 cells as determined by CCK-8 assay, *p < 0.05, **p < 0.01, compared with the group treated with DMSO
Baicalein inhibited the proliferation of MG-63 cells
The proliferation of osteosarcoma MG-63 cells treated with different concentrations of baicalein was determined by CCK-8 assay kit. As shown in Fig. 2b, there was no significant difference on the proliferation of MG-63 cells among the control, 10, 20, and 40 μg/ml treatment groups on day 1. But 2 days after treatment, in comparison to non-baicalein-treated group, the proliferation of MG-63 cells in all baicalein treatment groups was obviously weaker than control (DMSO) group (p < 0.05), and the proliferation of MG-63 cells in 40-μg/ml treatment group was most significantly inhibited (p < 0.01) compared with other treatment groups. Similarly, the proliferation ability of osteosarcoma MG-63 cells was substantially weakened in a concentration-dependent manner after they were treated with baicalein for 3 days. The proliferation of MG-63 cells in 40-μg/ml treatment group was the slowest in all treatment groups (p < 0.05). These findings suggested that baicalein reduced the viability of osteosarcoma MG-63 cells through inhibiting MG-63 cells’ proliferation.
Baicalein increased the apoptosis of MG-63 cells through phosphorylating JNK
As shown in Fig. 3b, c, the treatment of MG-63 cells with baicalein significantly (p < 0.01) increased the levels of apoptosis in a concentration-dependent manner, compared with that in untreated control group, and the apoptosis of 40-μg/ml baicalein treatment group was significantly higher than any other treatment groups. But this effect can be significantly inhibited by SP600125 (Fig. 3a, c). Quantitative analysis of apoptosis of baicalein-treated MG-63 cells with or without SP600125 was summarized in Fig. 3c. Additionally, it was found by Western blotting that baicalein (both 20 and 40 μg/ml) was able to significantly decrease the relative expression of p-JNK (Fig. 3d). These results indicated that baicalein-induced apoptosis via affecting JNK phosphorylation.
The effect of various concentrations of baicalein with (b) or without (a) SP600125 on the apoptosis of osteosarcoma MG-63 cells analyzed by flow cytometry. c Western blot analysis of phosphorylated JNK. d Quantitative analysis of apoptosis of MG-63 cells,*p < 0.05, **p < 0.01, compared with the group treated without SP600125
Baicalein suppressed c-MYC and β-catenin expressions of MG-63 cells through phosphorylating JNK
To further determine whether the promoting effect of baicalein on osteosarcoma MG-63 cells apoptosis is mediated through promoting the β-catenin degradation, Western blotting was used to analyze the expression of c-MYC and β-catenin in protein level after treatment with various concentrations of baicalein (10, 20, 40 μg/ml) for 24 h. As shown in Fig. 4a, b, c, the treatment of the cells with baicalein resulted in a dose-dependent reduction of c-MYC and β-catenin expression as compared with non-baicalein-treated controls. However, when the MG-63 cells were treated with baicalein and SP600125 together, the expressions of c-MYC and β-catenin were significantly (*p < 0.05) higher than those in the group treated without SP600125 (at the same concentration of baicalein). Moreover, real-time PCR was also used to detect the c-MYC and β-catenin expression in mRNA level. Data of c-MYC and β-catenin gene expressions were summarized in Fig. 4d, e. Similar with the proteins, the mRNA expressions of c-MYC and β-catenin decreased with the increasing concentrations of baicalein. But after the MG-63 cells were treated with both baicalein and SP600125, the expressions of c-MYC and β-catenin are significantly higher than those in the group treated only baicalein (without SP600125). These data revealed that baicalein inhibited the β-catenin accumulation via affecting JNK phosphorylation, thereby inhibiting the c-MYC expression.
The effect of baicalein with or without SP600125 on the expression of c-MYC and β-catenin in osteosarcoma MG-63 cells determined by Western blotting (a, b, c) and real-time PCR (e, f). *p < 0.05 and **p < 0.01 indicated significant and very significant differences, respectively, compared with the group treated without SP600125
BANCR was involved in the baicalein-induced apoptosis
In order to find a more detailed mechanism lies in the efficacy of baicalein in the inhibition of Wnt signaling, ectopic overexpression of the lncRNA BANCR, which was generally at an extremely low level in tumor cells, including osteosarcoma MG-63 cells (Fig. 5a), was performed via pcDNA3.1-BANCR transfection. Surprisingly, we found both pcDNA3.1-BANCR and baicalein significantly (p < 0.01) upregulated BANCR expression (Fig. 5b), downregulated the protein expressions of both β-catenin and p-JNK (Fig. 5c, d), and finally resulted in significantly attenuated cell viability (Fig. 5d). These results demonstrated that baicalein probably somehow promoted the BANCR expression which negatively regulated Wnt signaling transduction, thus suppressing the viability of osteosarcoma MG-63 cells.
BANCR was involved in baicalein’s inhibiting Wnt signaling transduction. a The low level of BANCR in MG-63 cells, compared with human osteoblast SV-HFO cells. b BANCR expression level was raised by pcDNA3.1-BANCR transfection and baicalein. c The protein expression of β-catenin was decreased by pcDNA3.1-BANCR transfection and baicalein. d The protein expressions of p-JNK and β-catenin were increased by pcDNA3.1-BANCR transfection and baicalein. e Viability of MG-63 cells was decreased by pcDNA3.1-BANCR transfection and baicalein. **p < 0.01, indicated a significant difference, compared with the cells only transfected with the empty vector pcDNA3.1
Discussion
Since the initial discovery of the oncogenic activity of Wnts in mouse mammary glands [12], the appreciation for the complex roles for Wnt signaling pathways in cancer has increased dramatically. Improved drug-discovery platforms and new technologies have facilitated the discovery of agents that can alter Wnt signaling in preclinical models, thus setting the stage for clinical trials in humans [13]. Baicalein has been shown to exert anti-tumor effects on various types of cancer [14]. However, little is known as to whether baicalein inhibits osteosarcoma cells viability, and if so, whether baicalein exerts through Wnt signaling pathway. This study firstly explored, the effects of baicalein in osteosarcoma cells and demonstrated that baicalein could induce cell death of osteosarcoma, which was suggested to be the induction of apoptosis (Fig. 3). Furthermore, we identified that combined with JNK inhibitor SP600125, the degradation of β-catenin was significantly declined, suggesting that Wnt signal was associated with the mechanism of baicalein’s anti-osteosarcoma effects, in which JNK was also involved.
Activation of canonical Wnt signaling has been associated with the decrease in apoptosis [15, 16]. Chen et al. reported that stable expression of Wnts-1 in Rat-1 cells suppressed apoptosis induced by either vincristine or vinblastine [17]. The suppression of apoptosis by Wnts-1 was demonstrated using assays such as DNA fragmentation, annexin V staining, cytochrome c release and caspase-9 activation. However, stable expression of a dominant negative T-cell-specific transcription factors blocked the reduction of programmed cell death (PCD) by Wnts-1. Although there are controversies as to the exact roles of canonical Wnt signaling involved in apoptosis, Wnt signaling has been demonstrated to relate to this process, which is consistent with our results.
Baicalein-mediated apoptosis has been described in other cell types [18–20], consistent with which, our present data revealed that baicalein was able to inhibit proliferation and induce apoptosis in osteosarcoma cells, as determined by CCK-8 assay kit (Fig. 2) and reflected by FACS of annexin V/propidium iodide-labeled cells (Fig. 3). Growth inhibitory effects of baicalein on breast cancer were shown to occur through arrest of cell cycle at G0/G1 phase and induction of apoptosis [21]. In an earlier study, baicalein was shown to induce apoptosis in human prostate cancer cells irrespective of their androgen responsiveness or p53 status [20]. These results suggest that the molecular targets of baicalein-mediated apoptosis probably vary in different cancer cells. Our study showed that baicalein could inhibit MG-63 cells proliferation and promote apoptosis by target Wnt pathway via β-catenin, which seems a new interpretation to baicalein’s anti-tumor mechanism.
Increased levels of β-catenin can initiate transcriptional activation of proteins, such as c-MYC, which control the G1 to S phase transition in the cell cycle. Entry into the S phase causes DNA replication and ultimately mitosis, which are responsible for cell proliferation [22]. Increased β-catenin expression is strongly correlated with poor prognosis in breast cancer patients [23]. This accumulation may be due to several factors, such as mutations in β-catenin, deficiencies in the β-catenin destruction complex, most frequently caused by mutations in structurally disordered regions of APC, overexpression of Wnt ligands, loss of inhibitors, and/or decreased activity of regulatory pathways (like Wnt/calcium pathway) [6]. Similar to these findings, we proved that the effect of baicalein on osteosarcoma MG-63 cell apoptosis was mediated through its promoting effect on β-catenin degradation, and the down-stream effector (c-MYC) of β-catenin was upregulated after adding SP600125, suggesting that baicalein probably executed its function through Wnt/JNK/β-catenin signaling.
Based on early discoveries linking the activation Wnt–catenin signaling to breast and colon carcinomas, it has generally been assumed that elevation of Wnt signaling promotes tumor initiation and progression [24–26]. Subsequent studies have suggested that this initial assumption may be an oversimplification. Instead, it seems that Wnt/β-catenin signaling can either promote or inhibit cancer progression in a context-dependent manner [13]. According to this information, our result should be cautiously interpreted. There may be other signal pathways or other mechanisms involved in the process. There are studies argue that aberrations in Wnt signaling cannot be targeted using a single universal strategy [13]. Future studies aimed at determining the mechanisms that control this context-dependency will be necessary to identify signaling nodes that could be targeted by therapeutic interventions.
Recently, long non-coding RNA (lncRNA) has been identified as a new player in cancer [27]. Dysregulated lncRNAs are involved in many types of cancer including osteosarcoma [28]. In this study, the level of the lncRNA BANCR was found extremely low in osteosarcoma MG-63 cells (Fig. 5a) as well as melanoma cells [29]. Therefore, we tried correlating its role and the anti-tumor effect of baicalein. To our delight, it was found that BANCR expression was positively correlated with baicalein (Fig. 5b). What is more, downregulation of BANCR promotes cell proliferation, migration, and metastasis of carcinoma [11, 30, 31], while its overexpression is correlated with significantly upregulated phosphorylated JNK (Fig. 5c), downregulated β-catenin (Fig. 5d), and suppressed cell viability of osteosarcoma (Fig. 5e). So, we speculated it probably somehow promoted the BANCR expression, then the overexpressed BANCR lead to JNK activation and β-catenin degradation successively, and in the end, caused the suppressed cell viability and promoted cell apoptosis of osteosarcoma. It is reported that BANCR can activate JNK to promote cell proliferation of carcinomas, such as melanoma and lung carcinoma both in vitro and in vivo [11, 31], but in reverse, we found in our study that BANCR-activated JNK signaling resulted in the decreased cell viability of osteosarcoma (Fig. 5). These contradicted findings may result from the dual role of JNK activation in apoptosis. There have already been various studies pointed out that JNK pathway simultaneously promoted and resisted apoptosis, which depended on cell type, nature of the death stimulus, and the activity of other signaling pathways [32]. Besides, in view of the fact that both BANCR and baicalein are able to affect other MAPK signaling transduction, like p38 and Erk [11, 33, 34], we suspect that not only Wnt signaling but also MAPK pathway may play roles in the baicalein-induced apoptosis, which still needs further validation.
In conclusion, baicalein could suppress the osteosarcoma cells viability by inhibiting c-MYC expression via Wnt signaling pathway, in which, JNK and the lncRNA BANCR were very likely to be involved as well as β-catenin.
References
Raymond AK, Jaffe N (2009) Osteosarcoma multidisciplinary approach to the management from the pathologist’s perspective. Cancer Treat Res 152:63–84. doi:10.1007/978-1-4419-0284-9_4
Chou AJ, Geller DS, Gorlick R (2008) Therapy for osteosarcoma: where do we go from here? Paediatr Drugs 10:315–327
Hanahan D, Weinberg RA (2011) Hallmarks of cancer: the next generation. Cell 144:646–674. doi:10.1016/j.cell.2011.02.013
Luetke A, Meyers PA, Lewis I, Juergens H (2014) Osteosarcoma treatment—where do we stand? A state of the art review. Cancer Treat Rev 40:523–532. doi:10.1016/j.ctrv.2013.11.006
Nusse R, Varmus H (2012) Three decades of Wnts: a personal perspective on how a scientific field developed. EMBO J 31:2670–2684. doi:10.1038/emboj.2012.146
Taketo MM (2004) Shutting down Wnt signal-activated cancer. Nat Genet 36:320–322. doi:10.1038/ng0404-320
MacDonald BT, Tamai K, He X (2009) Wnt/beta-catenin signaling: components, mechanisms, and diseases. Dev Cell 17:9–26. doi:10.1016/j.devcel.2009.06.016
Smeland S, Bruland OS, Hjorth L, Brosjo O, Bjerkehagen B, Osterlundh G, Jakobson A, Hall KS, Monge OR, Bjork O, Alvegaard TA (2011) Results of the Scandinavian Sarcoma Group XIV protocol for classical osteosarcoma: 63 patients with a minimum follow-up of 4 years. Acta Orthop 82:211–216. doi:10.3109/17453674.2011.566141
Esumi T, Makado G, Zhai H, Shimizu Y, Mitsumoto Y, Fukuyama Y (2004) Efficient synthesis and structure-activity relationship of honokiol, a neurotrophic biphenyl-type neolignan. Bioorg Med Chem Lett 14:2621–2625. doi:10.1016/j.bmcl.2004.02.067
Singh T, Katiyar SK (2013) Honokiol inhibits non-small cell lung cancer cell migration by targeting PGE(2)-mediated activation of beta-catenin signaling. PLoS One 8:e60749. doi:10.1371/journal.pone.0060749
Li R, Zhang L, Jia L, Duan Y, Li Y, Bao L, Sha N (2014) Long non-coding RNA BANCR promotes proliferation in malignant melanoma by regulating MAPK pathway activation. PLoS One 9:e100893
Tsukamoto AS, Grosschedl R, Guzman RC, Parslow T, Varmus HE (1988) Expression of the int-1 gene in transgenic mice is associated with mammary gland hyperplasia and adenocarcinomas in male and female mice. Cell 55:619–625
Anastas JN, Moon RT (2013) WNT signalling pathways as therapeutic targets in cancer. Nat Rev Cancer 13:11–26. doi:10.1038/nrc3419
Arora S, Singh S, Piazza GA, Contreras CM, Panyam J, Singh AP (2012) Honokiol: a novel natural agent for cancer prevention and therapy. Curr Mol Med 12:1244–1252
Hardt SE, Sadoshima J (2002) Glycogen synthase kinase-3beta: a novel regulator of cardiac hypertrophy and development. Circ Res 90:1055–1063
You L, Kim J, He B, Xu Z, McCormick F, Jablons DM (2006) Wnt-1 signal as a potential cancer therapeutic target. Drug News Perspect 19:27–31. doi:10.1358/dnp.2005.19.1.965871
Chen S, Guttridge DC, You Z, Zhang Z, Fribley A, Mayo MW, Kitajewski J, Wang CY (2001) Wnt-1 signaling inhibits apoptosis by activating beta-catenin/T cell factor-mediated transcription. J Cell Biol 152:87–96
Chae JI, Jeon YJ, Shim JH (2013) Downregulation of Sp1 is involved in honokiol-induced cell cycle arrest and apoptosis in human malignant pleural mesothelioma cells. Oncol Rep 29:2318–2324. doi:10.3892/or.2013.2353
Jeong JJ, Lee JH, Chang KC, Kim HJ (2012) Honokiol exerts an anticancer effect in T98G human glioblastoma cells through the induction of apoptosis and the regulation of adhesion molecules. Int J Oncol 41:1358–1364. doi:10.3892/ijo.2012.1582
Hahm ER, Arlotti JA, Marynowski SW, Singh SV (2008) Honokiol, a constituent of oriental medicinal herb magnolia officinalis, inhibits growth of PC-3 xenografts in vivo in association with apoptosis induction. Clin Cancer Res 14:1248–1257. doi:10.1158/1078-0432.CCR-07-1926
Hou W, Chen L, Yang G, Zhou H, Jiang Q, Zhong Z, Hu J, Chen X, Wang X, Yuan Y, Tang M, Wen J, Wei Y (2008) Synergistic antitumor effects of liposomal honokiol combined with adriamycin in breast cancer models. Phytother Res 22:1125–1132. doi:10.1002/ptr.2472
Kaldis P, Pagano M (2009) Wnt signaling in mitosis. Dev Cell 17:749–750. doi:10.1016/j.devcel.2009.12.001
Howe LR, Brown AM (2004) Wnt signaling and breast cancer. Cancer Biol Ther 3:36–41
Derksen PW, Tjin E, Meijer HP, Klok MD, Mac Gillavry HD, van Oers MH, Lokhorst HM, Bloem AC, Clevers H, Nusse R (2004) Illegitimate WNT signaling promotes proliferation of multiple myeloma cells. Proc Natl Acad Sci USA 101:6122–6127
Yu X, Wang Y, DeGraff DJ, Wills ML, Matusik RJ (2010) Wnt/β-Catenin activation promotes prostate tumor progression in a mouse model. Oncogene 30:1868–1879
Li Y, Bavarva JH, Wang Z, Guo J, Qian C, Thibodeau SN, Golemis EA, Liu W (2011) HEF1, a novel target of Wnt signaling, promotes colonic cell migration and cancer progression. Oncogene 30:2633–2643
Zhang H, Chen Z, Wang X, Huang Z, He Z, Chen Y (2013) Long non-coding RNA: a new player in cancer. J Hematol Oncol 6:1–7
J-p Li, L-h Liu, Li J, Chen Y, X-w Jiang, Y-r Ouyang, Y-q Liu, Zhong H, Li H, Xiao T (2013) Microarray expression profile of long noncoding RNAs in human osteosarcoma. Biochem Biophys Res Commun 433:200–206
Flockhart RJ, Webster DE, Qu K, Mascarenhas N, Kovalski J, Kretz M, Khavari PA (2012) BRAFV600E remodels the melanocyte transcriptome and induces BANCR to regulate melanoma cell migration. Genome Res 22:1006–1014
Sun M, Liu X-H, Wang K-M, F-q Nie, Kong R, J-s Yang, Xia R, Xu T-P, Jin F-Y, Liu Z-J (2014) Downregulation of BRAF activated non-coding RNA is associated with poor prognosis for non-small cell lung cancer and promotes metastasis by affecting epithelial–mesenchymal transition. Mol Cancer 13:68
Jiang W, Zhang D, Xu B, Wu Z, Liu S, Zhang L, Tian Y, Han X, Tian D (2015) Long non-coding RNA BANCR promotes proliferation and migration of lung carcinoma via MAPK pathways. Biomed Pharmacother 69:90–95
Jing L, Anning L (2005) Role of JNK activation in apoptosis: a double-edged sword. Cell Res 15:36–42
Stavniichuk R, Drel VR, Shevalye H, Maksimchyk Y, Kuchmerovska TM, Nadler JL, Obrosova IG (2011) Baicalein alleviates diabetic peripheral neuropathy through inhibition of oxidative–nitrosative stress and p38 MAPK activation. Exp Neurol 230:106–113
Q-m Zhou, Wang S, Zhang H, Y-y Lu, X-f Wang, Motoo Y, S-b Su (2009) The combination of baicalin and baicalein enhances apoptosis via the ERK/p38 MAPK pathway in human breast cancer cells. Acta Pharmacol Sin 30:1648–1658
Conflict of interest
The authors have no conflict of interest to report.
Author information
Authors and Affiliations
Corresponding author
Rights and permissions
About this article
Cite this article
He, N., Zhang, Z. Baicalein suppresses the viability of MG-63 osteosarcoma cells through inhibiting c-MYC expression via Wnt signaling pathway. Mol Cell Biochem 405, 187–196 (2015). https://doi.org/10.1007/s11010-015-2410-6
Received:
Accepted:
Published:
Issue Date:
DOI: https://doi.org/10.1007/s11010-015-2410-6